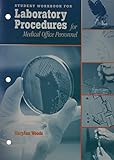
Amazon cover image

Results
|
|
121.
|

Image from Amazon.com
|
Social science in question / by
Material type:  Text Text
Publication details: London ; Thousand Oaks, Calif. : Sage Publications in association with the Open University, 1998
Availability: Items available for reference: Directorate of Library Services: Not For Loan (1)Call number: MED REF H61.S64 1998.
|
|
|
122.
|

Image from Amazon.com
|
|
|
|
123.
|

Image from Amazon.com
|
Sulzer centrifugal pump handbook /
Edition: 2nd ed.
Material type:  Text Text
Publication details: New York : Elsevier Advanced Technology, 1998
Availability: Items available for reference: Directorate of Library Services: Not For Loan (1)Call number: MED.REF TJ919.S94 1998.
|
|
|
124.
|

Image from Amazon.com
|
|
|
|
125.
|
|
Essentials of Neuroanatomy by
Edition: 1st edition
Material type:  Text Text
Publication details: Mumbai, MESH, 1998
Availability: Items available for reference: Directorate of Library Services: Not For Loan (1)Call number: MED.REF TCQM451.S3 1998.
|
|
|
126.
|

Image from Amazon.com
|
A neonatal vade-mecum / by
Edition: 3rd ed.
Material type:  Text Text
Publication details: London : New York : Arnold ; Oxford University Press, 1998
Availability: Items available for reference: Directorate of Library Services: Not For Loan (1)Call number: MED REF RJ253.N45.
|
|
|
127.
|

Image from Amazon.com
|
QBase anaesthesia:4 MCQs for the anaesthesia primary by
Material type:  Text Text
Publication details: New York Cambridge university press 1998
Availability: Items available for reference: Directorate of Library Services: Not For Loan (1)Call number: MED REF RD82.3.P38.
|
|
|
128.
|

Image from Amazon.com
|
The complete MRCP by
Edition: 2nd
Material type:  Text Text
Publication details: NewYork, Churchill livingstone, 1998
Availability: Items available for reference: Directorate of Library Services: Not For Loan (3)Call number: MED.REF R834.5 B49 1998, ...
|
|
|
129.
|

Image from Amazon.com
|
Essential statistics for medical examinations by
Material type:  Text Text
Publication details: London Pastest 1998
Availability: Items available for reference: Directorate of Library Services: Not For Loan (1)Call number: MED REF R837.E9M37.
|
|
|
130.
|

Image from Amazon.com
|
Essential statistics for medical examinations by
Material type:  Text Text
Publication details: Parkgate: Pastest, 1998
Availability: Items available for reference: Directorate of Library Services: Not For Loan (1)Call number: MED.RFR34.5.F37.
|
|
|
131.
|

Image from Amazon.com
|
Concise Pathology by
Edition: 3rd ed.
Material type:  Text Text
Publication details: London: Appleton and lange, 1998
Availability: Items available for reference: Directorate of Library Services: Not For Loan (1)Call number: MED.REF RB25 C475.
|
|
|
132.
|

Image from Amazon.com
|
Therapy research processes and practicalities / by
Material type:  Text Text
Publication details: Oxford ; Boston : Butterworth-Heinemann, 1998
Availability: Items available for reference: Directorate of Library Services: Not For Loan (1)Call number: MED.REFRM708.S43.
|
|
|
133.
|

Image from Amazon.com
|
Pediatric Anesthesia by
Edition: Atlas of anesthesia: v.7
Material type:  Text Text
Publication details: Hong Kong, Paramount printing group limited; 1998
Availability: Items available for reference: Directorate of Library Services: Not For Loan (2)Call number: MED.REF RD 139.P413, ...
|
|
|
134.
|

Image from Amazon.com
|
Textbook of radiology and imaging by
Edition: sixth edition
Material type:  Text Text
Publication details: London, Churchill Livingstone; 1998
Availability: Items available for reference: Directorate of Library Services: Not For Loan (2)Call number: MED.REF RC 78 T4, ...
|
|
|
135.
|

Image from Amazon.com
|
|
|
|
136.
|

Image from Amazon.com
|
Hematology and oncology pearls by
Material type:  Text Text
Publication details: New York Elsevier 1998
Availability: Items available for loan: Directorate of Library Services (1)Call number: MED RC262. F328.
|
|
|
137.
|

Image from Amazon.com
|
Essentials of human nutrition by
Material type:  Text Text
Publication details: Oxford : Oxford University Press, 1998
Availability: Items available for loan: Directorate of Library Services (1)Call number: MED QP141E82.
|
|
|
138.
|
Image from Amazon.com
|
|
|
|
139.
|

Image from Amazon.com
|
Political economy: a comperative approach by
Edition: 2nd ed.
Material type:  Text Text
Publication details: London Praeger 1998
Availability: Items available for loan: Directorate of Library Services (3)Call number: MED. HB90.C52, ...
|
|
|
140.
|

Image from Amazon.com
|
Dental anatomy histology and development by
Material type:  Text Text
Publication details: New Delhi Arya(MEDI) 1998
Availability: Items available for loan: Directorate of Library Services (2)Call number: MED RK280.B47, ...
|
